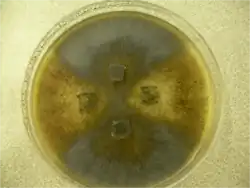
De donkerbruine en de bruine isolaten in een kruisingsonderzoek.

Gezellig mestvaasje
| Gezellig mestvaasje | |||||||||||||||
|---|---|---|---|---|---|---|---|---|---|---|---|---|---|---|---|
_40X.png)
| |||||||||||||||
| Perithecium | |||||||||||||||
| Taxonomische indeling | |||||||||||||||
| |||||||||||||||
| Soort | |||||||||||||||
| Sordaria fimicola (Roberge ex Desm.) Ces. & De Not. (1863) | |||||||||||||||
| Afbeeldingen op | |||||||||||||||
| |||||||||||||||
Gezellig mestvaasje (Sordaria fimicola) is een schimmel, die behoort tot de orde Sordariales van de ascomyceten. De schimmel komt algemeen voor in de uitwerpselen van planteneters. Het aantal chromosomen is n = 7.
Het mycelium en de perithecia zijn donkerbruin, maar er komen ook grijze, bruine en kleurloze mutanten voor. De kleur ontstaat door de melanine in de sporewand en de melaninevorming wordt bepaald door de twee allelen g en t. g+ is het allel van het normale (wilde) isolaat en g die van de mutant. t+ is het allel van het normale (wilde) isolaat en t die van de mutant. Heeft de ascospore de allelen g+ en t+ dan is de ascosporewand donkerbruin, bij g+ en t bruin, bij g en t+ grijs en bij g en t kleurloos.
Het perithecium is 291,5 - 550 × (185-) 200 - 425 µm en de nek 90 - 125 × 60 - 100 µm. De cellen van het peridium zijn 15 - 213 µm groot. De sporenzakjes zijn 127,5 - 202,5 × 13,7 - 17,5 (22,5) µm groot en de ascosporen 15 - 20 × 10 - 12,5 µm.[1]
De sporenzakjes groeien door de ostiole naar het licht toe (fototropie), waardoor de ascosporen door overdruk in het sporenzakje naar het licht toe weggeschoten worden.
-
De donkerbruine en de bruine isolaten in een kruisingsonderzoek.
De donkerbruine en de bruine isolaten in een kruisingsonderzoek. -
 Uit het perithecium vrijkomende sporenzakjes met ascosporen (100x).
Uit het perithecium vrijkomende sporenzakjes met ascosporen (100x). -
Woronin-lichaampjes (zie pijlen) liggen tegen de celwand van Sordaria fimicola, terwijl het cytoplasma door de opening stroomt.
De schimmeldraden zijn op karakteristieke wijze in compartimenten verdeeld door septen (interne wanden). Deze geven de schimmeldraad stevigheid en verhinderen grootschalig verlies van cytoplasma als in de celwand een breuk optreedt. De meeste septen hebben in het midden een kleine opening waardoor celplasma en ook celkernen zich min of meer vrij door de hele schimmeldraad kunnen bewegen. Bij schimmeldraadbreuk sluiten Woronin-lichaampjes de opening in de tussenwand af, waardoor de celinhoud van de aanliggende compartimenten niet kan wegstromen.[2][3]
Genetica
_160X.png)
Sordaria fimicola is zeer geschikt voor de bestudering van de genetica. Het heeft een korte levenscyclus van gewoonlijk 7 - 12 dagen en is gemakkelijk te kweken op een voedingsbodem. De soort is homothallisch en een isolaat is haploïde. Ook zijn er gemakkelijk vele mutanten te induceren met verschillend gekleurde ascosporen, waardoor ze geschikt zijn voor de bestudering van de recombinatie in de meiose.[4][5][6] Bij de meiose worden in eerste instantie vier haploïde ascosporen gevormd, die gevolgd wordt door nog een deling, een mitose, zodat er zich acht ascosporen bevinden in het sporenzakje. Aan de kleur van de ascospore is te zien van welke ouder ze afkomstig zijn. De analyse van de recombinatie is gemakkelijker door de volgorde van de meiose producten in de ascospore.[7] De ascosporen liggen namelijk op één rij.
- ↑ Trans. Tsuneo WATANABE Three species of Sordaria, and Eudarluca biconica from cherry seeds, Mycol. Soc. Japan 3: 3-4, 199. Gearchiveerd op 18 september 2016.
- ↑ Chua, N. H., Jedd G., A new self-assembled peroxisomal vesicle required for efficient resealing of the plasma membrane, Nature Cell Biology, 2, 4 blz. 226–231, 2000, doi:10.1038/35008652, PMID 10783241
- ↑ Yuan P., Jedd G., Kumaran D. Swaminathan S., Shio H., Hewitt D., Chua N. H., Swaminathan K., A HEX-1 crystal lattice required for Woronin body function in Neurospora crassa, Nature Structural Biology, 10, 4, blz. 264-270, 2003, doi:10.1038/nsb910, PMID 12640443
- ↑ Biofacts Publication No. 11138 Add Up and Cross Over Sordaria Genetics Simulation
- ↑ Jon C. Glase Chapter 1 A Study of Gene Linkage and Mapping Using Tetrad Analysis in the Fungus Sordaria fimicola
- ↑ Introductory Mycology. John Wiley and Sons (1996), 361. ISBN 0-471-52229-5.
- ↑ Mogelijke combinaties van ascosporenvolgorde zonder en met overkruising. Gearchiveerd op 22 oktober 2020.